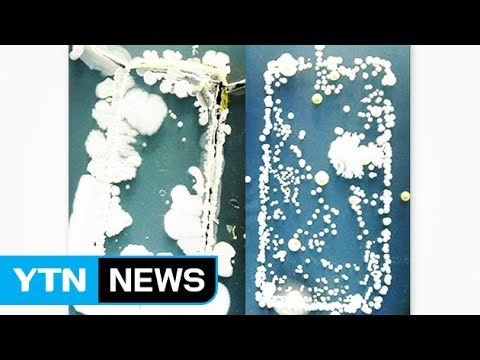

티스토리 뷰
목차
“당신의 스마트폰, 변기보다 7배 더 더럽습니다.” 이 말을 들으면, 믿기 어렵죠? 그런데 이게 단순한 자극적 표현이 아니에요.
실제로 영국 레스터대 프림로즈 프리스톤 교수는 “스마트폰은 대장균, 녹농균 같은 감염성 세균의 온상”이라고 경고했더라고요.
특히 화장실에서 스마트폰을 사용하는 순간, 당신 손에 들어온 세균은 단순히 ‘더럽다’ 수준이 아니에요. 당신의 입, 얼굴, 음식, 그리고 면역력 약한 아이에게까지 고스란히 옮겨질 수 있다는 사실, 알고 계셨나요?
저도 솔직히, 화장실 갈 때 스마트폰은 기본 장착이었거든요ㅎㅎ 근데 이거 알고 나선… 왠지 손이 찝찝하더라고요. 그렇다면, 도대체 왜 스마트폰이 세균의 주범이 된 걸까요? 그리고 우린 이걸 어떻게 막아야 할까요? 아래에서 하나씩 풀어볼게요!



스마트폰, 화장실보다 더 더럽다고?
레스터대학교 임상미생물학 교수인 프림로즈 프리스톤은 최근 데일리메일과의 인터뷰에서 이렇게 말했어요.
“휴대전화는 대장균, 녹농균 같은 감염성 세균의 주요 매개체가 될 수 있습니다.”
그녀는 특히 화장실에서 스마트폰을 사용하는 행위를 강하게 경고했어요. 심지어 스마트폰 표면에 존재하는 세균 수는 변기보다 7배 이상 많다고도 했죠.
네~ 그 변기요. 그 더럽다고 피하는 바로 그곳보다, 우리가 하루 종일 손에 쥐고 있는 스마트폰이 더 ‘세균 천국’이라는 겁니다.



왜 스마트폰은 세균이 많을까?
- 항상 손에 있다
한 연구에 따르면, 사람은 하루 평균 2,600번 이상 스마트폰을 만진다고 해요. 우리가 솔직히 핸드폰이 한 몸이나 마찬가지지 않나요. 그러니 손에 있는 세균이 고스란히 스마트폰에 옮겨가죠. - 습기 + 온기 = 세균 번식 최적 환경
특히 화장실은 습하고 따뜻해서, 세균이 자라기에 딱 좋은 곳이에요. 그 공간에 스마트폰을 들고 들어가면? 네, 결과는 뻔하죠. - 청소는 거의 안 함
스마트폰은 매일 쓰지만, 청소는 언제 했는지 기억도 안 나죠? 세균은 매일 쌓이는데 닦질 않으니, 당연히 계속 더러워지는 겁니다.



스마트폰 청결, 어떻게 지켜야 할까?
그렇다면 우린 스마트폰의 세균으로부터 어떻게 살아남아야 할까요?
✔ 화장실엔 스마트폰 NO!
정말 급할 땐 어쩔 수 없지만, 습관적으로 들고 들어가는 건 멈춰야 해요.
✔ 알코올 솜이나 전용 클리너로 자주 닦기
적어도 하루 한 번은 스마트폰을 소독해 보세요. 생각보다 뽀득~하게 닦이면 기분도 좋아요ㅎㅎ
✔ 가죽 케이스는 자주 교체하거나 관리
가죽 재질은 세균 번식이 더 쉬우니, 정기적으로 교체하거나 소독을 추천드려요.
✔ 특히 어린 아이나 노약자와 함께 사는 집이라면 필수!
면역력이 약한 가족 구성원이 있다면, 스마트폰 청결은 선택이 아니라 필수입니다.

아직도 스마트폰을 들고 화장실 가시나요?
괜찮아요, 저도 그랬으니까요. 하지만 이제는 좀 달라져야겠죠? 정말 필요한 순간이 아니라면, 스마트폰을 잠시 밖에 두는 습관이 우리 몸 건강을 지키는 시작일 수 있어요.
“스마트폰은 정보의 창이기도 하지만, 세균의 창구가 되기도 합니다.” 이 문장이 괜한 말은 아니더라고요…



📌 더 자세한 연구 내용과 실제 실험 결과가 궁금하다면?
👉 이데일리 기사 바로 보기
📌 전문가의 설명이 담긴 영상도 한 번 보세요
